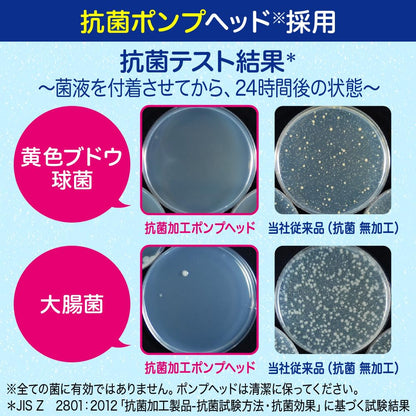
Biore U Foaming Hand Soap Refill Osmanthus Scent 770Ml Quasi-Drug

Biore U Foaming Hand Soap Refill Osmanthus Scent 770Ml Quasi-Drug
Pairs well with
Import duties, taxes, and charges are customer's duty. Details here.
Ship directly from Japan
60-day return window

Biore U Foaming Hand Soap Refill Osmanthus Scent 770Ml Quasi-Drug
Product Infomation
Description
Biore U Foaming Hand Soap Refill Osmanthus Scent 770Ml Quasi-Drug offers a gentle yet effective cleansing experience for your hands. Its refreshing osmanthus scent provides a pleasant fragrance while thoroughly removing dirt and impurities. This foaming formula is designed to keep your hands feeling soft and clean without dryness.
This hand soap refill is ideal for the whole family, providing a convenient and economical way to maintain hand hygiene. The quasi-drug formula ensures a safe and reliable cleansing action. With its large 770ml volume, it is perfect for frequent use in households or offices.
Details
• Format: Refill pouch
• Net contents: 770 ml
• Manufacturer: Kao
Features
- Gentle foaming hand soap with refreshing osmanthus scent
- Quasi-drug formulation for effective cleansing
- Keeps hands soft and moisturized after use
- Large 770ml refill pouch for economical use
- Suitable for daily use by the whole family
How to use
Refill your hand soap dispenser with Biore U Foaming Hand Soap Refill. Pump a small amount onto wet hands and lather thoroughly. Rinse well with water. Use daily, especially before meals and after outdoor activities, to maintain clean and soft hands.
About Japan With Love
Japan With Love was established in December 2020 with great experiences and understanding of Japanese products. We provide a wide range of cosmetics, supplements, foods, kitchenware, and more. They are manufactured & shipped directly from Japan with a 100% authentic guarantee.
If you have any questions, you are always welcome to contact us. We'll get back to you as soon as possible, within 24 hours on weekdays.
-
Shipping Information
Use this text to answer questions in as much detail as possible for your customers.
-
Customer Support
Use this text to answer questions in as much detail as possible for your customers.
-
FAQ’s
Use this text to answer questions in as much detail as possible for your customers.
-
Contact Us
Use this text to answer questions in as much detail as possible for your customers.
If you have any questions, you are always welcome to contact us. We'll get back to you as soon as possible, within 24 hours on weekdays.
FAQs
Please read our FAQs page to find out more.
Are your products authentic?
Yes, all our items are 100% authentic and shipped directly from Japan. We work only with official partners and trusted suppliers.
Do you offer free shipping?
We occasionally offer shipping discounts. Check current rates at checkout and subscribe here for updates on promotions, tips, and more. For all shipping-related details, please visit our Shipping Policy page.
What is Shipping Protection and why should I choose it?
Shipping Protection is an optional add-on that covers loss, theft, or damage during transit. For peace of mind, we highly recommend selecting it at checkout, especially for international orders.
Do I have to pay customs duties or import taxes?
Yes. Import fees are the responsibility of the customer and vary by country. Please check your local regulations before ordering.
Can I return or exchange an item?
Yes, we offer a 60-day return window for items that arrive damaged, defective, or incorrect. Read more about our Return Policy.
Do I need an account to place an order?
No, you can check out as a guest. But creating an account allows for faster checkout, order tracking, and managing your preferences.


